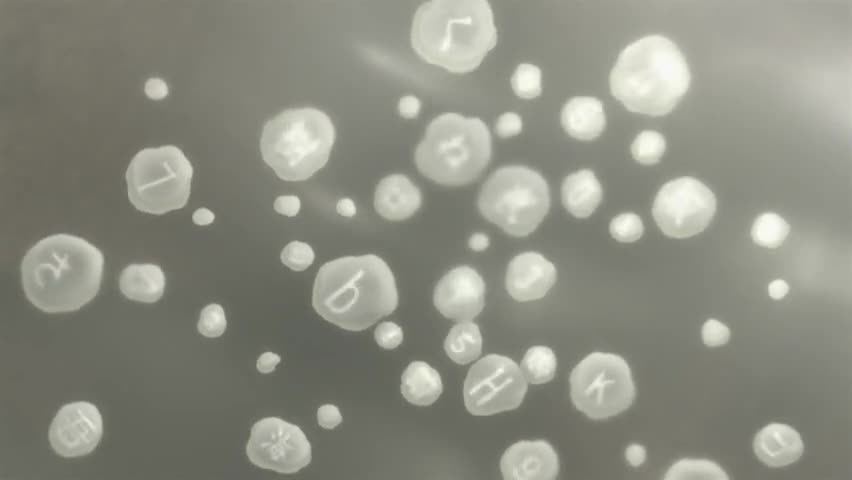

Un-Go

ANIMATION EXPLORER
GLOBAL RATING
 6.60 / 10
6.60 / 10
 7.36 / 10
7.36 / 10
INFORMATION
- Age: 17+
- Main Type: ANIME
- Publish Date: 2011-10-14
- Session: Fall
- Type: TV
-
Theme:
-
Genre:
-
Status:
STUDIOS/PRODUCERS
PLOT
The dismal future Japan featured in Un-Go. The Japanese government chooses to abrogate Article 9 of the Japanese Constitution and mobilizes its self-defense forces in retribution after an unnamed war and several terrorist assaults eventually reach the mainland. In an effort to halt terrorism and future attacks on the nation, the Japanese government introduces the "Information Privacy and Protection Act" after the war-torn nation eventually experiences a period of uneasy peace. The Act grants Rinroku Kaishou, a tech firm CEO, power over a huge monitoring network that can gather information from almost every connected device in the nation and is ostensibly used to combat all types of crime. A traditional detective named Shinjr Yuki and his supernatural partner Inga are the central characters of Un-Go. In contrast to the valiant Rinroku, Shinjr appears at a crime scene at the wrong time and draws the incorrect conclusions, giving him the moniker "The Defeated Detective." In reality, however, Shinjr is frequently requested by Rinroku or the Public Prosecutors Office when the case's issue is too delicate for routine investigation. While Rinroku will spin his conclusion to fit a narrative that would comfort a population still suffering from the war, Shinjr always looks deeper to unearth the truth thanks to his logical abilities and Inga's particular ability.